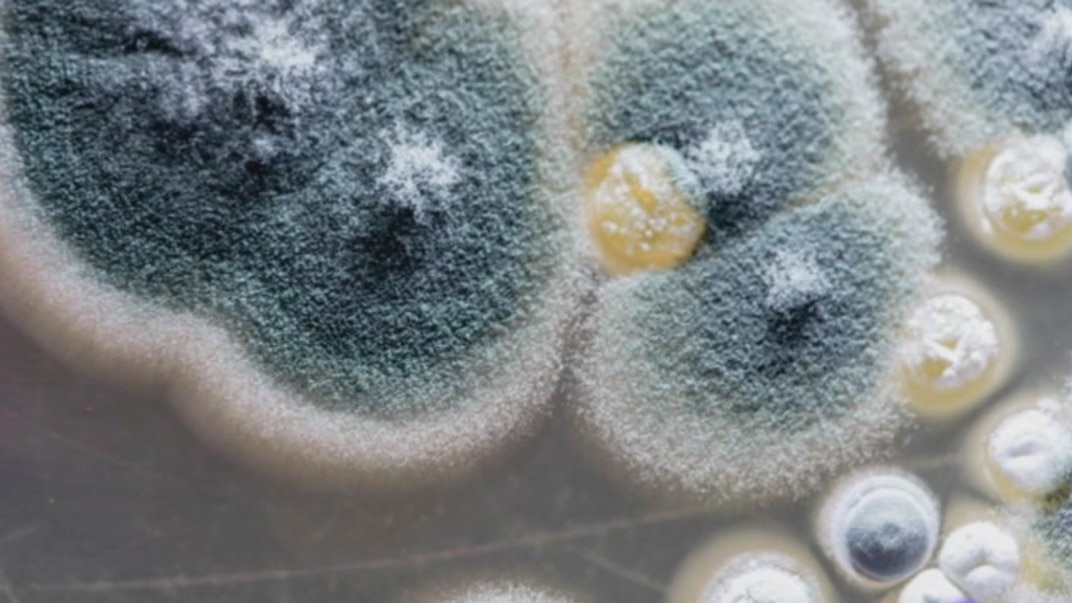

'Rotting from the inside out:' Investigators say woman had mold growing on her body
A disabled woman who was supposed to be in her children care has died in San Antonio. Investigators say she spent her final days rotting from the inside out.
A disabled woman who was supposed to be in her children care has died in San Antonio. Investigators say she spent her final days rotting from the inside out.